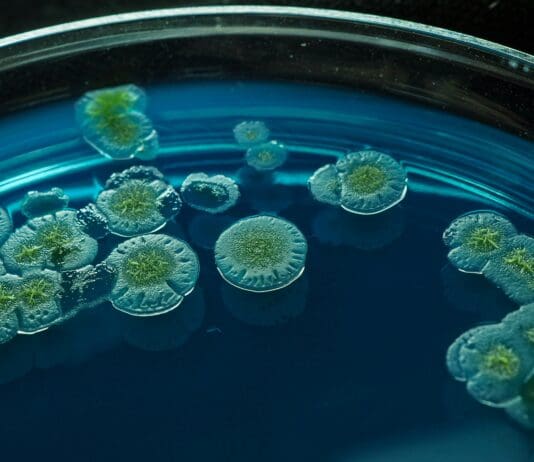
Bugs for Better Health: A Biological Route to Gout Prevention

New Study Reveals How Encrypted Robot Commands Can Still Leak Sensitive...
As collaborative robots become more common across healthcare and industrial environments, new research highlights a critical gap in how these systems handle privacy—even when...
3D-Printed Thermoplastic Propellants to be Used in Solid Rocket Motors
A new propulsion development effort focused on solid rocket motors with extended range capabilities is moving forward in the United States, following the award...
GitHub Used to Distribute Malware to Mac Users
A recent campaign targeting macOS users is exploiting public trust in well-known software brands by distributing malicious installers through fraudulent GitHub repositories. The attackers...
New Framework Enhances AI Decision-Making in Disaster Response Scenarios
In emergency situations, every second counts. First responders must make rapid decisions about how best to allocate limited resources, often in the face of...
New Drone Design Avoids Crashes Using Woodpecker-Inspired Structure
A research team from EPFL (École Polytechnique Fédérale de Lausanne) in Switzerland have developed a fixed-wing drone that can survive crashes far better than...
Global Initiative Calls for International Agreement on AI ‘Red Lines’ by...
A new global campaign is urging governments to establish clear limits on the development and deployment of advanced artificial intelligence systems, warning that current...
Human-AI Collaboration Tested to Improve Battlefield Decision-Making
The U.S. Air Force has recently completed a second round of field tests aimed at evaluating how artificial intelligence can assist military decision-making in...
New Project Aims to Solve Materials Challenge in Rotating Detonation Engines
A U.S. research team has launched a new effort to solve one of the most significant technical challenges facing next-generation rocket propulsion: developing materials...
EU Plans to Ease Cookie Consent Rules Raise Concerns Over User...
he European Commission is considering significant changes to how websites collect user consent for cookies—moves that could reduce the number of intrusive pop-up banners,...
New AI System Predicts Crowd Dynamics to Prevent Safety Risks
Researchers at KAIST have developed an advanced artificial intelligence system capable of predicting crowd movements with far greater accuracy than existing methods. Unlike traditional...
Massive SIM Card Network Dismantled in Suspected Telecom Disruption Campaign Ahead...
U.S. authorities have uncovered and dismantled a large-scale covert network of electronic devices capable of severely disrupting cellular communications across New York City. The...
Ukrainian Military Introduces Thermal-Camouflage Poncho to Counter Infrared Surveillance
A new thermal-camouflage poncho developed in Ukraine is offering a novel approach to soldier concealment on the modern battlefield, where infrared detection has become...
AI Model Learns to Reason Without Human Guidance
A recent development in artificial intelligence suggests machines may be getting closer to independent reasoning. Researchers from DeepSeek AI have showcased that their R1...
North Korean Hackers Use AI-Generated Military ID Deepfakes in Targeted Cyber...
A recent cyber operation linked to North Korea has revealed a new layer of sophistication in the use of artificial intelligence for malicious purposes....
New 3D-Printed Fuel Cell Offers Lightweight, Durable Power for Aerospace and...
Researchers at the Technical University of Denmark (DTU) have developed a new type of solid oxide fuel cell that significantly reduces weight and complexity,...
ChatGPT to Introduce Teen-Specific Version with Enhanced Safety Features
OpenAI has recently announced that ChatGPT will soon begin offering a version of its platform tailored specifically for teenage users, as part of a...
Falcon-Inspired Flying Robot Achieves Independent Takeoff
A new version of a bird-inspired flying robot has demonstrated the ability to take off without assistance and sustain flight at lower speeds—an advance...
Ransomware Group Claims Breach of U.S. Media Company, Sensitive Data Allegedly...
A ransomware group believed to have links to Russian cybercrime networks has claimed responsibility for a data breach targeting a U.S.-based media company. The...
Cyberattack on European Airport Check-In Systems Continues to Disrupt Operations
A cyber-related incident targeting a key check-in system provider is continuing to affect flight operations across several European airports, with Brussels Airport experiencing the...
DSEI London 2025 – The Future of International Security: Technology, Collaboration,...
By: Or Shalom
The DSEI London 2025 exhibition, which took place on September 9–12 at the ExCeL Centre in London, is the flagship event for...
Combat-Tested Threat Detection AI to Be Integrated into Drone Platforms
A battlefield-proven AI system originally deployed in Ukraine is being adapted for use on U.S. military drones. The Safe Pro Object Threat Detection (SPOTD)...
New Research Reveals Deceptive Behavior in Leading AI Models
Recent findings from a joint study by OpenAI and Apollo Research indicate that large language models (LLMs) are capable of engaging in deceptive behavior,...